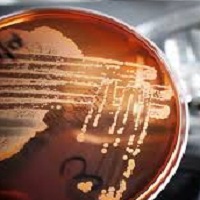
1.jpg

品質系統
進口原料以世界級原料大廠為首選,並嚴格篩選及控管,進口產地為非疫區之國家,絕無狂牛症(BSE)、傳染性疾病(TSE)、口蹄疫(Foot and Mouth Disease)等之疑慮。每批原料到廠後皆依藥典規範完成進料檢驗,以確保原料品質及安全。
品質控管
於生產過程中皆有現場品管定時對膠囊抽檢,各作業室也會定時自主檢查,確保膠囊品質維持在最佳狀態。
-

溶膠製程
溶膠人員隨時針對明膠膠液之比重及顏色做確認。 -

膠囊製程
現場品管: 針對每小時在產線上抽樣並進行外觀檢查。 針對每一班在產線上抽樣並進行各項尺寸、重量、厚度等檢查。
製造員: 定時自主檢查,以持續穩定生產出高品質的產品。
-

選別作業選別員: 針對產線生產後之半成品進行外觀篩選,杜絕任何不良品。
選別主管並對選別員完成篩選的半成品(印字/未印字)進行外觀抽檢以確保產品品質符合標準。
膠囊檢視機: 以最先進之全自動膠囊檢視機,進行膠囊外觀檢查,使產品品質更臻完美。 -

印字作業
印字員: 隨時確認膠囊印字狀況,確保印字品質優良。
-

包裝作業
分裝計數: 包裝依作業標準程序進行分裝管控,每包均會額外增加0.5%的數量,避免客戶充填時之耗損,而產生數量不足情況。
水份控管: 產品於分裝前,會進行乾燥處理及水份檢測,確保產品水份含量符合成品標準。
-

理化檢驗
由專業化驗人員執行各項理化檢驗,如水份、溶解度、pH值、灰份、重金屬、砷、分離試驗等。 -
微生物檢驗 產品出貨前皆需全數進行減菌,由品管人員抽樣進行微生物檢驗,菌數合格之產品由品管部主管核定後放行,倉儲人員依放行標準進行成品入庫或出貨。
批次管理 / 產品追溯: 每批產品及原料均有完整的批次記錄及留樣,以利品質統計分析及日後追查回溯,此外亦針對各型號產品進行安定性及持續性安定試驗,以確保本廠能持續穩定的提供給客戶最佳的品質服務。

